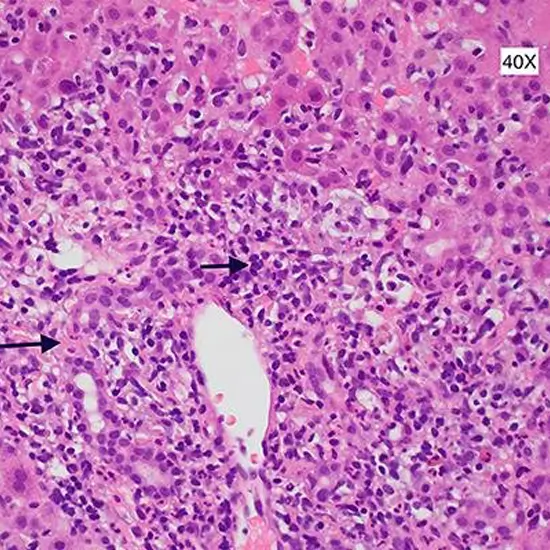

Book Liver Biopsy Panel Appointment Online Near me at the best price in Delhi/NCR from Ganesh Diagnostic. NABL & NABH Accredited Diagnostic centre and Pathology lab in Delhi offering a wide range of Radiology & Pathology tests. Get Free Ambulance & Free Home Sample collection. 24X7 Hour Open. Call Now at 011-47-444-444 to Book your Liver Biopsy Panel at 50% Discount.
Histopathology liver biopsy is a procedure to draw out a small piece of liver tissue to examine under a microscope. This procedure is to diagnose liver disease or damage and its severity.
Doctors recommend this procedure when other test findings indicate liver issues but are unable to find them exactly. It is helpful in the diagnosis of the problems and the stages of the problems such as chronic hepatitis B or C, alcoholic liver, Wilson’s disease, and biliary cirrhosis, etc. It also helps doctors in the treatment plan and monitors the effects of ongoing treatment. This test is taken as post liver transplant procedure to monitor the condition of the liver.
To prepare for the procedure, you need to follow the instructions given by your healthcare provider.
Liver Biopsy Procedure is safe but has some possible temporary risks such as pain at the site of biopsy, bleeding, and infection.
Contact Ganesh Diagnostic and Imaging Centre (GDIC) for a liver biopsy panel for the detection and treatment of the problems at the earliest.
| Test Type | Liver Biopsy Panel |
| Includes | Histopathology Liver Biopsy Panel Test (Histopathology) |
| Preparation | |
| Reporting | Within 24 hours* |
| Test Price |
₹ 1500
|

Early check ups are always better than delayed ones. Safety, precaution & care is depicted from the several health checkups. Here, we present simple & comprehensive health packages for any kind of testing to ensure the early prescribed treatment to safeguard your health.